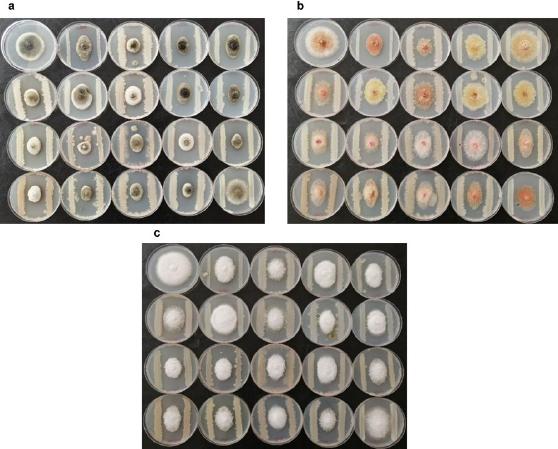
Antagonism effect of the nineteen selected strains based on their enzymatic activities. Control on the top left followed by each bacterial strain to the bottom right of each panel: HGG11, OTG3’> OTG9’> OTG6, OTR1, OTR2, OTK3, OTK1, OTK4, OTK8, OTK9, HGG7, HGG9, HGG15, HGG16, HGR5, HGK5, HGK11, HGK1, against a) Alternaria alternata; b) Fusarium gramine arum; c) Phytophthora infestans.

Fig. 1.
Fig. 2.

Fig. 3.

Fig. 4.

Fig. 5.

Fig. 6.

BGCs encoding secondary metabolites discovered by the AntiSMASH server in the Bacillus halotolerans HGR5 genome along with the closest biosynthetic gene clusters detected by ClusterKnownBlast and listed in the MIBiG database_
| Cluster | Predicted size (bp) | BGC type | Compound | MIBiG accession | Similarity | Closest strain |
|---|---|---|---|---|---|---|
| 1 | 41,419 | other | bacilycin | BGC0001184 | Bacillus velezensis FZB42 | 100% |
| 2 | 21,613 | sactipeptide | subtilosin A | BGC0000602 | Bacillus subtilis subsp. spizizenii ATCC® 6633™ | 100% |
| 3 | 47,140 | NPRS | bacillibactin | BGC0000309 | Bacillus subtilis subsp. subtilis str. 168 | 100% |
| 4 | 106,121 | NRPS, transAT-PKS | bacillaene | BGC0001089 | Bacillus velezensis FZB42 | 100% |
| 5 | 79,855 | NRPS | fengycin | BGC0001095 | Bacillus velezensis FZB42 | 80% |
| NRPS, transAT-PKS | mycosubtilin | BGC0001103 | Bacillus subtilis subsp. spizizenii ATCC® 6633™ | 100% | ||
| 6 | 41,098 | T3PKS | - | - | - | - |
| 7 | 21,899 | terpene | - | - | - | - |
| 8 | 65,396 | NRPS | surfactin | BGC0000433 | Bacillus velezensis FZB42 | 86% |
| 9 | 20,807 | terpene | - | - | - | - |
| 10 | 51,225 | PKS | myxovirescin A1 | BGC0001025 | Myxococcus xanthus DK 1622 | 13% |
| macrolactin H | BGC0000181 | Bacillus velezensis FZB42 | 40% | |||
| 11 | 32,261 | PKS | macrobrevin | BGC0001470 | Brevibacillus sp. Leaf182 | 26% |
| phormidolide | BGC0001350 | Leptolyngbya sp. ISBN3-Nov-94-8 | 21% | |||
| 12 | 13,175 | NRPS | fengycin | BGC0001095 | Bacillus velezensis FZB42 | 20% |
| plipastatin | BGC0000407 | Bacillus subtilis subsp. subtilis | 38% | |||
| 13 | 10,326 | NRPS | plipastatin | BGC0000407 | Bacillus subtilis subsp. subtilis | 23% |
| fengycin | BGC0001095 | Bacillus velezensis FZB42 | 20% | |||
| 14 | 7,314 | PKS | bryostatin | BGC0000174 | Candidatus Endobugula sertula | 100% |